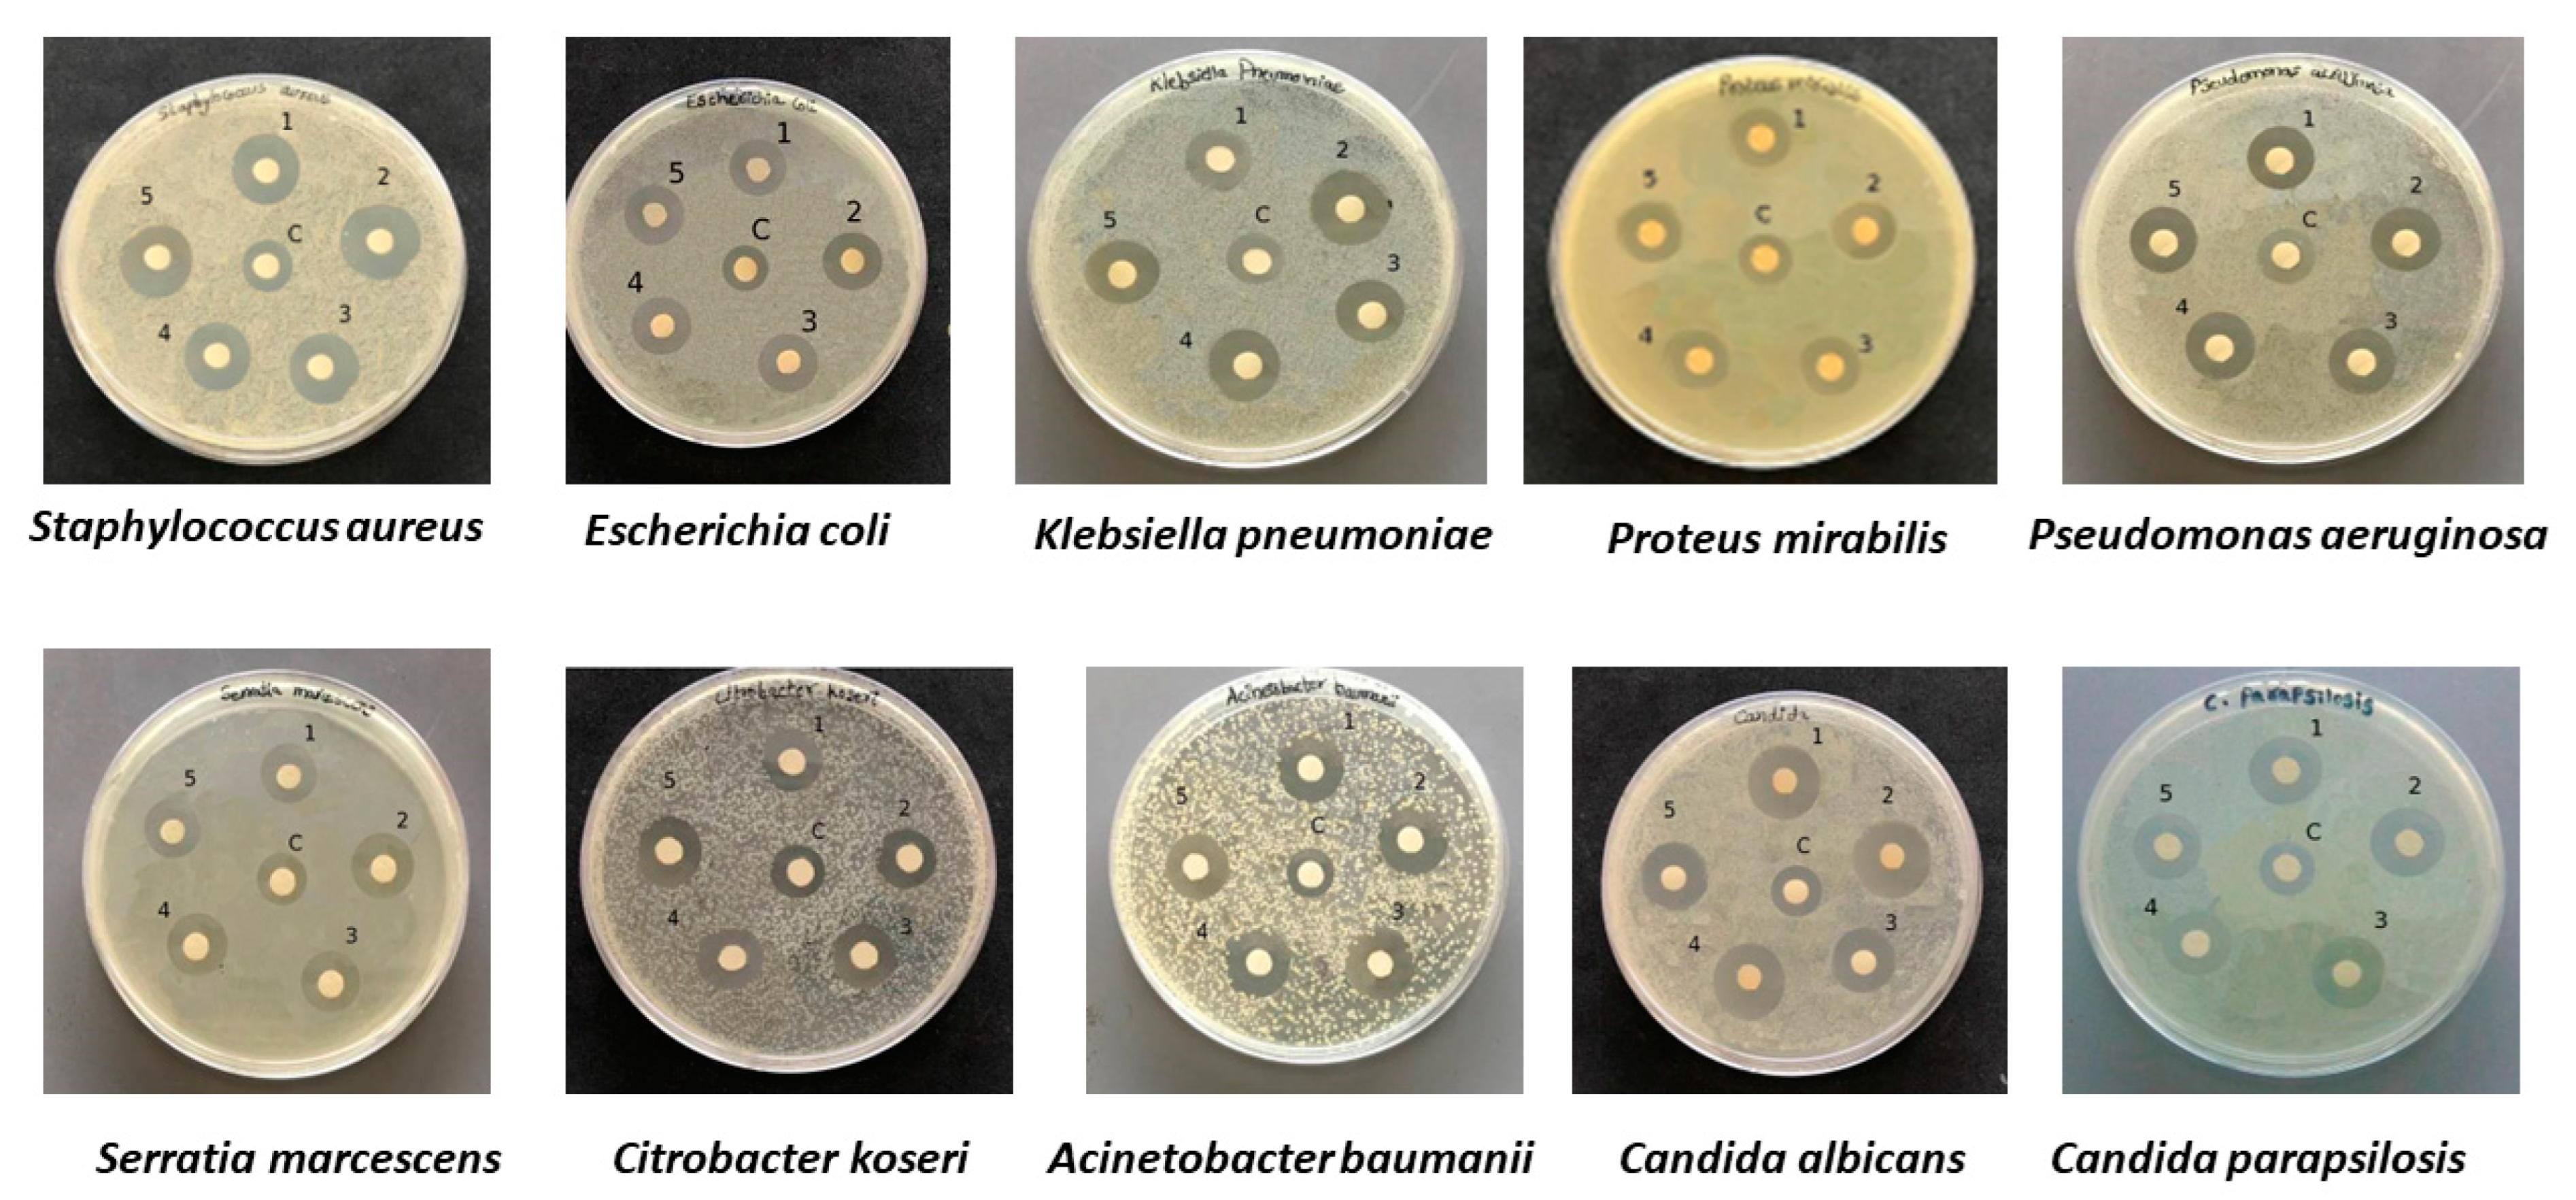
Marinedrugs 20 00558 g004

Synthesis of Bioactive Silver Nanoparticles Using New Bacterial Strains from an Antarctic Consortium
Abstract
:1. Introduction
2. Results and Discussion
2.1. Biosynthesis and UV–Visible Spectroscopy of Ag NPs
2.2. Morphology and Chemical Composition of Bacterial AgNPs
2.3. Antibacterial and Antifungal Activities of Bacterial Ag NPs
2.4. MIC and MBC Assay
3. Materials and Methods
3.1. Culture and Chemicals
3.2. AgNP Biosynthesis and Purification
3.3. AgNP Characterization: UV–Vis Absorption Spectra and Zeta Potential Measurements
3.3.1. Scanning Electron Microscopy (SEM) and Transmission Electron Microscopy (TEM)
3.3.2. Dynamic Light Scattering and Zeta Potential Measurements
3.3.3. Energy-Dispersive X-ray Analysis (EDAX), Fourier-Transform Infrared Spectroscopy (FTIR) Analysis and Powder X-ray Diffraction (XRD)
3.4. Kirby–Bauer Disk Diffusion Susceptibility Test
3.5. Minimum Inhibitory Concentration (MIC) and Minimum Bactericidal Concentration (MBC) Evaluation
4. Conclusions
Supplementary Materials
Author Contributions
Funding
Institutional Review Board Statement
Data Availability Statement
Acknowledgments
Conflicts of Interest
References
- Chu, W.-L.; Dang, N.-L.; Kok, Y.-Y.; Yap, K.-S.I.; Phang, S.-M.; Convey, P. Heavy metal pollution in Antarctica and its potential impacts on algae. Polar Sci. 2018, 20, 75–83. [Google Scholar] [CrossRef]
- Vallesi, A.; Pucciarelli, S.; Buonanno, F.; Fontana, A.; Mangiagalli, M. Bioactive molecules from protists: Perspectives in biotechnology. Eur. J. Protistol. 2020, 75, 125720. [Google Scholar] [CrossRef] [PubMed]
- Khan, I.; Saeed, K.; Khan, I. Nanoparticles: Properties, applications, and toxicities. Arab. J. Chem. 2019, 12, 908–931. [Google Scholar] [CrossRef]
- Iravani, S.; Korbekandi, H.; Mirmohammadi, S.V.; Zolfaghari, B. Synthesis of silver nanoparticles: Chemical, physical and biological methods. Res. Pharm. Sci. 2014, 9, 385–406. [Google Scholar]
- Gandhi, H.; Khan, S. Biological Synthesis of Silver Nanoparticles and Its Antibacterial Activity. J. Nanomed. Nanotechnol. 2016, 7, 1000366. [Google Scholar] [CrossRef]
- Mancini, A.; Pucciarelli, S. Antibiotic activity of the antioxidant drink effective Microorganism-X (EM-X) extracts against common nosocomial pathogens: An in vitro study. Nat. Prod. Res. 2018, 34, 1575–1580. [Google Scholar] [CrossRef]
- Gouyau, J.; Duval, R.; Boudier, A.; Lamouroux, E. Investigation of Nanoparticle Metallic Core Antibacterial Activity: Gold and Silver Nanoparticles against Escherichia coli and Staphylococcus aureus. Int. J. Mol. Sci. 2021, 22, 1905. [Google Scholar] [CrossRef]
- Jain, A.S.; Pawar, P.S.; Sarkar, A.; Junnuthula, V.; Dyawanapelly, S. Bionanofactories for Green Synthesis of Silver Nanoparticles: Toward Antimicrobial Applications. Int. J. Mol. Sci. 2021, 22, 11993. [Google Scholar] [CrossRef]
- Hulkoti, N.I.; Taranath, T.C. Biosynthesis of nanoparticles using microbes—A review. Colloids Surf. B Biointerfaces 2014, 121, 474–483. [Google Scholar] [CrossRef]
- Dakal, T.C.; Kumar, A.; Majumdar, R.S.; Yadav, V. Mechanistic basis of antimicrobial actions of silver nanoparticles. Front. Microbiol. 2016, 7, 1831. [Google Scholar] [CrossRef]
- Javed, R.; Zia, M.; Naz, S.; Aisida, S.O.; Ain, N.U.; Ao, Q. Role of capping agents in the application of nanoparticles in biomedicine and environmental remediation: Recent trends and future prospects. J. Nanobiotechnol. 2020, 18, 172. [Google Scholar] [CrossRef] [PubMed]
- Sanyasi, S.; Majhi, R.K.; Kumar, S.; Mishra, M.; Ghosh, A.; Suar, M.; Satyam, P.V.; Mohapatra, H.; Goswami, C.; Goswami, L. Polysaccharide-capped silver Nanoparticles inhibit biofilm formation and eliminate multi-drug-resistant bacteria by disrupting bacterial cytoskeleton with reduced cytotoxicity towards mammalian cells. Sci. Rep. 2016, 6, 24929. [Google Scholar] [CrossRef] [PubMed]
- Pucciarelli, S.; La Terza, A.; Ballarini, P.; Barchetta, S.; Yu, T.; Marziale, F.; Passini, V.; Methé, B.; Detrich, H.W., 3rd; Miceli, C. Molecular cold-adaptation of protein function and gene regulation: The case for comparative genomic analyses in marine ciliated protozoa. Mar. Genom. 2009, 2, 57–66. [Google Scholar] [CrossRef] [PubMed]
- Mozzicafreddo, M.; Pucciarelli, S.; Swart, E.C.; Piersanti, A.; Emmerich, C.; Migliorelli, G.; Ballarini, P.; Miceli, C. The macronuclear genome of the Antarctic psychrophilic marine ciliate Euplotes focardii reveals new insights on molecular cold adaptation. Sci. Rep. 2021, 11, 18782. [Google Scholar] [CrossRef]
- Pucciarelli, S.; Chiappori, F.; Sparvoli, D.; Milanesi, L.; Miceli, C.; Melki, R. Tubulin folding: The special case of a beta-tubulin isotype from the Antarctic psychrophilic ciliate Euplotes focardii. Polar Biol. 2013, 36, 1833–1838. [Google Scholar] [CrossRef]
- Chiappori, F.; Pucciarelli, S.; Merelli, I.; Ballarini, P.; Miceli, C.; Milanesi, L. Structural thermal adaptation of β-tubulins from the Antarctic psychrophilic protozoan Euplotes focardii. Proteins Struct. Funct. Bioinform. 2012, 80, 1154–1166. [Google Scholar] [CrossRef]
- Pischedda, A.; Ramasamy, K.P.; Mangiagalli, M.; Chiappori, F.; Milanesi, L.; Miceli, C.; Pucciarelli, S.; Lotti, M. Antarctic marine ciliates under stress: Superoxide dismutases from the psychrophilic Euplotes focardii are cold-active yet heat tolerant enzymes. Sci. Rep. 2018, 8, 14721. [Google Scholar] [CrossRef]
- Yang, G.; Aprile, L.; Turturo, V.; Pucciarelli, S.; Pucciarelli, S.; Miceli, C. Characterization and comparative analysis of psychrophilic and mesophilic alpha-amylases from Euplotes species: A contribution to the understanding of enzyme thermal adaptation. Biochem. Biophys. Res. Commun. 2013, 438, 715–720. [Google Scholar] [CrossRef]
- Yang, G.; De Santi, C.; de Pascale, D.; Pucciarelli, S.; Pucciarelli, S.; Miceli, C. Characterization of the first eukaryotic cold-adapted patatin-like phospholipase from the psychrophilic Euplotes focardii: Identification of putative determinants of thermal-adaptation by comparison with the homologous protein from the mesophilic Euplotes crassus. Biochimie 2013, 95, 1795–1806. [Google Scholar]
- Pucciarelli, S.; Devaraj, R.R.; Mancini, A.; Ballarini, P.; Castelli, M.; Schrallhammer, M.; Petroni, G.; Miceli, C. Microbial Consortium Associated with the Antarctic Marine Ciliate Euplotes focardii: An Investigation from Genomic Sequences. Microb. Ecol. 2015, 70, 484–497. [Google Scholar] [CrossRef]
- Ramasamy, K.P.; Telatin, A.; Mozzicafreddo, M.; Miceli, C.; Pucciarelli, S. Draft Genome Sequence of a New Pseudomonas sp. Strain, ef1, Associated with the Psychrophilic Antarctic Ciliate Euplotes focardii. Microbiol. Resour. Announc. 2019, 8, e00867-19. [Google Scholar] [CrossRef] [PubMed]
- Orlando, M.; Pucciarelli, S.; Lotti, M. Endolysins from Antarctic Pseudomonas Display lysozyme activity at low temperature. Mar. Drugs. 2020, 18, 579. [Google Scholar] [CrossRef] [PubMed]
- Mangiagalli, M.; Lapi, M.; Maione, S.; Orlando, M.; Brocca, S.; Pesce, A.; Barbiroli, A.; Camilloni, C.; Pucciarelli, S.; Lotti, M.; et al. The co-existence of cold activity and thermal stability in an Antarctic GH42 β-galactosidase relies on its hexameric quaternary arrangement. FEBS J. 2020, 288, 546–565. [Google Scholar] [CrossRef] [PubMed]
- Mangiagalli, M.; Bar-Dolev, M.; Tedesco, P.; Natalello, A.; Kaleda, A.; Brocca, S.; de Pascale, D.; Pucciarelli, S.; Miceli, C.; Braslavsky, I.; et al. Cryo-protective effect of an ice-binding protein derived from Antarctic bacteria. FEBS J. 2016, 284, 163–177. [Google Scholar] [CrossRef] [PubMed]
- John, M.S.; Nagoth, J.A.; Ramasamy, K.P.; Ballarini, P.; Mozzicafreddo, M.; Mancini, A.; Telatin, A.; Liò, P.; Giuli, G.; Natalello, A.; et al. Horizontal gene transfer and silver nanoparticles production in a new Marinomonas strain isolated from the Antarctic psychrophilic ciliate Euplotes focardii. Sci. Rep. 2020, 10, 10218. [Google Scholar] [CrossRef]
- John, M.S.; Nagoth, J.A.; Ramasamy, K.P.; Mancini, A.; Giuli, G.; Natalello, A.; Ballarini, P.; Miceli, C.; Pucciarelli, S. Synthesis of bioactive silver nanoparticles by a pseudomonas strain associated with the Antarctic psychrophilic proto-zoon Euplotes focardii. Mar. Drugs 2020, 18, 38. [Google Scholar] [CrossRef]
- John, M.; Nagoth, J.; Zannotti, M.; Giovannetti, R.; Mancini, A.; Ramasamy, K.; Miceli, C.; Pucciarelli, S. Biogenic Synthesis of Copper Nanoparticles Using Bacterial Strains Isolated from an Antarctic Consortium Associated to a Psychrophilic Marine Ciliate: Characterization and Potential Application as Antimicrobial Agents. Mar. Drugs 2021, 19, 263. [Google Scholar] [CrossRef]
- Saravanan, M.; Vemu, A.K.; Barik, S.K. Rapid biosynthesis of silver nanoparticles from Bacillus megaterium (NCIM 2326) and their antibacterial activity on multi drug resistant clinical pathogens. Colloids Surf. B Biointerfaces 2011, 88, 325–331. [Google Scholar] [CrossRef]
- Kalimuthu, K.; Babu, R.S.; Venkataraman, D.; Bilal, M.; Gurunathan, S. Biosynthesis of silver nanocrystals by Bacillus licheniformis. Colloids Surf. B Biointerfaces 2008, 65, 150–153. [Google Scholar] [CrossRef]
- Priyadarshini, S.; Gopinath, V.; Priyadharsshini, N.M.; MubarakAli, D.; Velusamy, P. Synthesis of anisotropic silver nanoparticles using novel strain, Bacillus flexus and its biomedical application. Colloids Surf. B Biointerfaces 2013, 102, 232–237. [Google Scholar] [CrossRef]
- Kulkarni, R.; Deobagkar, D.; Zinjarde, S. Nanoparticles derived from Rhodococcus roppenstedtii as bioactive agents for controlling aquaculture associated bacterial pathogens. Aquaculture 2022, 547, 737538. [Google Scholar] [CrossRef]
- Otari, S.V.; Patil, R.M.; Nadaf, N.H.; Ghosh, S.J.; Pawar, S.H. Green biosynthesis of silver nanoparticles from an actinobacteria Rhodococcus sp. Mater. Lett. 2012, 72, 92–94. [Google Scholar] [CrossRef]
- Panacek, A.; Kvitek, L.; Prucek, R.; Kolar, M.; Vecerova, R.; Pizurova, N.; Sharma, V.K.; Nevecna, T.; Zboril, R. Silver colloid nanoparticles: Synthesis, characterization, and their antibacterial activity. J. Phys. Chem. B 2006, 110, 16248–16253. [Google Scholar] [CrossRef] [PubMed]
- Dada, A.O.; Adekola, F.A.; Dada, F.E.; Adelani-Akande, A.T.; Bello, M.O.; Okonkwo, C.R.; Inyinbor, A.A.; Oluyori, A.P.; Olayanju, A.; Ajanaku, K.O.; et al. Silver nanoparticle synthesis by Acalypha wilkesiana extract: Phytochemical screening, characterization, influence of operational parameters, and preliminary antibacterial testing. Heliyon 2019, 5, e02517. [Google Scholar] [CrossRef] [PubMed]
- Jovanović, Ž.; Radosavljević, A.; Šiljegović, M.; Bibić, N.; Mišković-Stanković, V.; Kačarević-Popović, Z. Structural and optical characteristics of silver/poly(N-vinyl-2-pyrrolidone) anosystems synthesized by γ-irradiation. Radiat. Phys. Chem. 2012, 81, 1720–1728. [Google Scholar] [CrossRef]
- Kondiah, P.P.D.; Choonara, Y.E.; Kondiah, P.J.; Marimuthu, T.; Kumar, P.; du Toit, L.C.; Modi, G.; Pillay, V. Nanocomposites for therapeutic application in multiple sclerosis. In Woodhead Publishing Series in Biomaterials, Applications of Nanocomposite Materials in Drug Delivery; Woodhead Publishing: Cambridge, UK, 2018; pp. 391–408. [Google Scholar]
- Shivaji, S.; Madhu, S.; Singh, S. Extracellular synthesis of antibacterial silver nanoparticles using psychrophilic bacteria. Process Biochem. 2011, 46, 1800–1807. [Google Scholar] [CrossRef]
- Ahmad, S.A.; Das, S.S.; Khatoon, A.; Ansari, M.T.; Afzal, M.; Hasnain, S.; Nayak, A.K. Bactericidal activity of silver nanoparticles: A mechanistic review. Mater. Sci. Energy Technol. 2020, 3, 756–769. [Google Scholar] [CrossRef]
- Qing, Y.; Cheng, L.; Li, R.; Liu, G.; Zhang, Y.; Tang, X.; Wang, J.; Liu, H.; Qin, Y. Potential antibacterial mechanism of silver nanoparticles and the optimization of orthopedic implants by advanced modification technologies. Int. J. Nanomed. 2018, 13, 3311–3327. [Google Scholar] [CrossRef]
- Liao, C.; Li, Y.; Tjong, S.C. Bactericidal and Cytotoxic Properties of Silver Nanoparticles. Int. J. Mol. Sci. 2019, 20, 449. [Google Scholar] [CrossRef]
- Bhattacharjee, S. DLS and zeta potential—What they are and what they are not? J. Control Release. 2016, 235, 337–351. [Google Scholar] [CrossRef]
- Hudzicki, J. Kirby-Bauer Disk Diffusion Susceptibility Test Protoco; American Society for Microbiology: Washington, DC, USA, 2009. [Google Scholar]
- Bauer, A.W.; Kirby, W.M.; Sherris, J.C.; Turck, M. Antibiotic susceptibility testing by a standardized single disk method. Am. J. Clin. Pathol. 1966, 45, 496. [Google Scholar] [CrossRef]
- CLSI Document EP100-S23; Clinical and Laboratory Standards Institute: Wayne, PA, USA, 2019; Available online: https://clsi.org/media/2663/m100ed29_sample.pdf (accessed on 1 January 2021).

| Antibacterial Activity of Bio AgNPs | ||||||||||||||||
|---|---|---|---|---|---|---|---|---|---|---|---|---|---|---|---|---|
| Pathogenic Bacteria | Marinomonas ef1 | Pseudomonas ef1 | Rhodococcus ef1 | Brevundimonas ef1 | Bacillus ef1 | |||||||||||
| Diameter of Inhibition Zone (mm) | ||||||||||||||||
| T1 | C1 | IZS3 (T-C) | T1 | C1 | IZS3 (T-C) | T1 | C1 | IZS3 (T-C) | T1 | C1 | IZS3 (T-C) | T1 | C1 | C2 | IZS3 (T-C) | |
| GRAM-POSITIVE BACTERIA | ||||||||||||||||
| Staphylococcus aureus | 15 ± 0.2 | 9 ± 0.4 | 6 ± 0.2 | 13 ± 0.1 | 9 ± 0.2 | 4 ± 0.1 | 16 ± 0.3 | 9 ± 0.2 | 7 ± 0.1 | 16 ± 0.1 | 9 ± 0.4 | 7 ± 0.3 | 15 ± 0.2 | 9 ± 0.4 | 17 ± 0.4 | 6 ± 0.2 |
| GRAM-NEGATIVE BACTERIA | ||||||||||||||||
| Escherichia coli | 17 ± 0.3 | 10 ± 0.4 | 7 ± 0.1 | 16 ± 0.2 | 10 ± 0.1 | 6 ± 0.1 | 16 ± 0.2 | 10 ± 0.4 | 6 ± 0.2 | 17 ± 0.2 | 10 ± 0.1 | 7 ± 0.1 | 16 ± 0.5 | 10 ± 0.2 | 9 ± 0.2 | 6 ± 0.3 |
| Klebsiella pneumoniae | 16 ± 0.5 | 10 ± 0.2 | 6 ± 0.3 | 16 ± 0.3 | 10 ± 0.5 | 6 ± 0.2 | 15 ± 0.2 | 10 ± 0.3 | 5 ± 0.1 | 17 ± 0.5 | 10 ± 0.4 | 7 ± 0.1 | 16 ± 0.1 | 10 ± 0.3 | 10 ± 0.5 | 6 ± 0.2 |
| Pseudomonas aeruginosa | 15 ± 0.2 | 11 ± 0.5 | 4 ± 0.3 | 15 ± 0.2 | 11 ± 0.4 | 4 ± 0.2 | 17 ± 0.3 | 11 ± 0.5 | 6 ± 0.2 | 16 ± 0.4 | 11 ± 0.2 | 5 ± 0.2 | 15 ± 0.2 | 11 ± 0.3 | 15 ± 0.2 | 4 ± 0.1 |
| Proteus mirabilis | 14 ± 0.3 | 10 ± 0.1 | 4 ± 0.2 | 15 ± 0.4 | 10 ± 0.2 | 5 ± 0.2 | 15 ± 0.4 | 10 ± 0.3 | 5 ± 0.1 | 14 ± 0.2 | 10 ± 0.4 | 4 ± 0.2 | 15 ± 0.4 | 10 ± 0.2 | 12 ± 0.2 | 5 ± 0.2 |
| Citrobacter koseri | 15 ± 0.4 | 10 ± 0.3 | 5 ± 0.1 | 16 ± 0.2 | 10 ± 0.3 | 6 ± 0.1 | 15 ± 0.2 | 10 ± 0.4 | 5 ± 0.2 | 15 ± 0.3 | 10 ± 0.2 | 5 ± 0.1 | 16 ± 0.2 | 10 ± 0.1 | R | 6 ± 0.1 |
| Acinetobacter baumanii | 14 ± 0.5 | 11 ± 0.2 | 3 ± 0.3 | 16 ± 0.2 | 11 ± 0.1 | 5 ± 0.1 | 17 ± 0.2 | 11 ± 0.6 | 6 ± 0.4 | 15 ± 0.5 | 11 ± 0.2 | 4 ± 0.3 | 15 ± 0.4 | 11 ± 0.2 | R | 4 ± 0.2 |
| Serratia marcescens | 14 ± 0.3 | 10 ± 0.5 | 4 ± 0.2 | 14 ± 0.2 | 10 ± 0.1 | 4 ± 0.1 | 15 ± 0.4 | 10 ± 0.1 | 5 ± 0.3 | 15 ± 0.2 | 10 ± 0.1 | 5 ± 0.1 | 14 ± 0.4 | 10 ± 0.3 | 18 ± 0.2 | 4 ± 0.1 |
| FUNGI | ||||||||||||||||
| Candida albicans | 14 ± 0.4 | 11 ± 0.1 | 3 ± 0.3 | 17 ± 0.6 | 11 ± 0.5 | 6 ± 0.1 | 16 ± 0.4 | 11 ± 0.3 | 5 ± 0.1 | 16 ± 0.2 | 11 ± 0.3 | 5 ± 0.1 | 18 ± 0.2 | 11 ± 0.3 | 12 ± 0.5 | 7 ± 0.1 |
| Candida parapsilosis | 12 ± 0.1 | 11 ± 0.2 | 1 ± 0.1 | 16 ± 0.5 | 11 ± 0.3 | 5 ± 0.2 | 19 ± 0.2 | 11 ± 0.1 | 8 ± 0.1 | 17 ± 0.4 | 11 ± 0.1 | 6 ± 0.3 | 16 ± 0.5 | 11 ± 0.3 | 14 ± 0.4 | 5 ± 0.1 |
| Pathogenic Bacteria | Rhodococcus ef1 | Brevundimonas ef1 | Bacillus ef1 | |||
|---|---|---|---|---|---|---|
| MIC µg/mL | MBC μg/mL | MIC µg/mL | MBC μg/mL | MIC µg/mL | MBC μg/mL | |
| GRAM-POSITIVE BACTERIA | ||||||
| Staphylococcus aureus (ATCCV@25923) | 25 ± 0.4 | 25 ± 0.2 | 25 ± 0.2 | 25 ± 0.1 | 12.5 ± 0.2 | 12.5 ± 0.3 |
| GRAM-NEGATIVE BACTERIA | ||||||
| Escherichia coli (ATCCV@25922) | 12.5 ± 0.2 | 25 ± 0.2 | 25 ± 0.4 | 25 ± 0.1 | 12.5 ± 0.2 | 12.5 ± 0.4 |
| Klebsiella pneumoniae (ATCCV@13883) | 12.5 ± 0.4 | 25 ± 0.3 | 12.5 ± 0.4 | 25 ± 0.2 | 12.5 ± 0.2 | 25 ± 0.3 |
| Pseudomonas aeruginosa (ATCCV@27853) | 12.5 ± 0.2 | 25 ± 0.2 | 12.5 ± 0.2 | 25 ± 0.3 | 12.5 ± 0.4 | 12.5 ± 0.4 |
| Proteus mirabilis (ATCCV@35659) | 6.25 ± 0.3 | 12.5 ± 0.5 | 6.25 ± 0.3 | 12.5 ± 0.4 | 6.25 ± 0.4 | 12.5 ± 0.2 |
| Citrobacter koseri (ATCCV@ 25408) | 12.5 ± 0.5 | 12.5 ± 0.4 | 12.5 ± 0.3 | 25 ± 0.2 | 12.5 ± 0.3 | 12.5 ± 0.2 |
| Acinetobacter baumanii (ATCCV@ 19606) | 12.5 ± 0.2 | 12.5 ± 0.2 | 12.5 ± 0.4 | 25 ± 0.3 | 12.5 ± 0.4 | 12.5 ± 0.2 |
| Serratia marcescens (ATCCV@13880) | 3.12 ± 0.3 | 12.5 ± 0.2 | 6.25 ± 0.3 | 12.5 ± 0.2 | 3.12 ± 0.5 | 12.5 ± 0.5 |
| FUNGI | ||||||
| Candida albicans (ATCCV@ 90028) | 12.5 ± 0.5 | 25 ± 0.2 | 12.5 ± 0.4 | 25 ± 0.4 | 12.5 ± 0.3 | 25 ± 0.3 |
| Candida parapsilosis (ATCCV@22019) | 12.5 ± 0.4 | 25 ± 0.5 | 12.5 ± 0.4 | 25 ± 0.5 | 6.25 ± 0.3 | 12.5 ± 0.4 |
Publisher’s Note: MDPI stays neutral with regard to jurisdictional claims in published maps and institutional affiliations. |
© 2022 by the authors. Licensee MDPI, Basel, Switzerland. This article is an open access article distributed under the terms and conditions of the Creative Commons Attribution (CC BY) license (https://creativecommons.org/licenses/by/4.0/).
Share and Cite
John, M.S.; Nagoth, J.A.; Ramasamy, K.P.; Mancini, A.; Giuli, G.; Miceli, C.; Pucciarelli, S. Synthesis of Bioactive Silver Nanoparticles Using New Bacterial Strains from an Antarctic Consortium. Mar. Drugs 2022, 20, 558. https://doi.org/10.3390/md20090558
John MS, Nagoth JA, Ramasamy KP, Mancini A, Giuli G, Miceli C, Pucciarelli S. Synthesis of Bioactive Silver Nanoparticles Using New Bacterial Strains from an Antarctic Consortium. Marine Drugs. 2022; 20(9):558. https://doi.org/10.3390/md20090558
Chicago/Turabian StyleJohn, Maria Sindhura, Joseph Amruthraj Nagoth, Kesava Priyan Ramasamy, Alessio Mancini, Gabriele Giuli, Cristina Miceli, and Sandra Pucciarelli. 2022. "Synthesis of Bioactive Silver Nanoparticles Using New Bacterial Strains from an Antarctic Consortium" Marine Drugs 20, no. 9: 558. https://doi.org/10.3390/md20090558
APA StyleJohn, M. S., Nagoth, J. A., Ramasamy, K. P., Mancini, A., Giuli, G., Miceli, C., & Pucciarelli, S. (2022). Synthesis of Bioactive Silver Nanoparticles Using New Bacterial Strains from an Antarctic Consortium. Marine Drugs, 20(9), 558. https://doi.org/10.3390/md20090558








